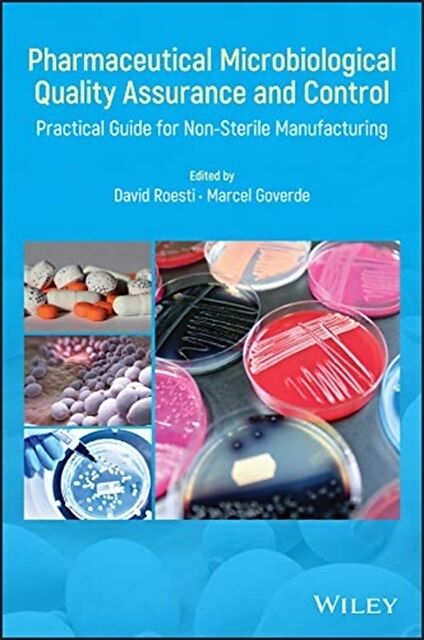

Pharmaceutical Microbiological Quality Assurance and Control
Beschreibung
Lieferung vom Verlag mit leichten Qualitätsmängeln möglich Autorentext David Roesti, PhD, works at Novartis Pharma AG in Stein, Switzerland, and is responsible for defining the microbial control strategy at the site and is a global subject matter expert in mic...Format auswählen
- Fester EinbandCHF 214.00
Wird oft zusammen gekauft
Andere Kunden kauften auch
Beschreibung
Lieferung vom Verlag mit leichten Qualitätsmängeln möglich
Autorentext
David Roesti, PhD, works at Novartis Pharma AG in Stein, Switzerland, and is responsible for defining the microbial control strategy at the site and is a global subject matter expert in microbiology for the Novartis group. He is also is an elected member of the General Chapters Microbiology Expert Committee of the Unites States Pharmacopoeia 2015?2020 revision cycle. Marcel Goverde, PhD, runs MGP Consulting GmbH for consulting, training and project management in GMP-relevant areas with a focus on microbiology, hygiene and deviation management. He is the Swiss expert in the EDQM group for Modern Microbiological Methods since 2003, which was then integrated into Group 1 (Microbiological Methods and Statistical Analysis) in 2015.
Klappentext
Relying on practical examples from the authors' experience, this book provides a thorough and modern approach to controlling and monitoring microbial contaminations during the manufacturing of non-sterile pharmaceuticals. Offers a comprehensive guidance for non-sterile pharmaceuticals microbiological QA/QC Presents the latest developments in both regulatory expectations and technical advancements Provides guidance on statistical tools for risk assessment and trending of microbiological data Describes strategy and practical examples from the authors' experience in globalized pharmaceutical companies and expert networks Offers a comprehensive guidance for non-sterile pharmaceuticals microbiological QA/QC Presents the latest developments in both regulatory expectations and technical advancements Provides guidance on statistical tools for risk assessment and trending of microbiological data Describes strategy and practical examples from the authors' experience in globalized pharmaceutical companies and expert networks
Inhalt
Editors xix
List of Contributors xxi
Preface xxvii
Foreword xxxiii
Acknowledgments xxxv
1 Microbiological Control Strategy 1
*David Roesti and Marcel Goverde*
1.1 Introduction 1
1.2 Overview of a Microbial Control Strategy Program 2
1.3 Main Factors to Be Controlled 4
1.4 Conclusion 18
Bibliography 18
2 Microbial Contamination Risk Assessment in Non sterile Drug Product Manufacturing and Risk Mitigation 23
*Tony Cundell*
2.1 Introduction 24
2.2 Regulatory, Compendia, and Industry Guidance 24
2.3 Putting into Perspective the Microbiological Risk Associated with Non sterile Products 25
2.4 Risk Assessment Tools 29
2.5 Organizational Risk Management Maturity 35
2.6 Hierarchy of Risks 35
2.7 Effect of Product Attributes 46
2.8 Emerging Manufacturing Technologies 48
2.9 A Case History 52
2.10 Conclusions 53
Bibliography 53
3 Qualification of Microbiological Laboratory Personnel and Equipment 57
*Robert Schwarz*
3.1 Introduction 57
3.2 Reasons, Requirements, and Strategies for Qualification 58
3.3 Critical Aspects of Microbiological Methods 68
3.4 Practical Examples for Qualification of Laboratory Personnel 72
Acknowledgments 76
Bibliography 76
4 Introduction to Culture Media in Pharmaceutical Microbiology for Non sterile Products 79
*Marion Louis, Laurent Leblanc, and Félix A. Montero Julian*
4.1 Introduction 80
4.2 Culture Media Challenges and Development 83
4.3 Importance of Culture Media for Patient Safety 83
4.4 Culture Media are all Different 83
4.5 Innovation in Regard to Culture Media 91
4.6 Quality Controls 92
4.7 Culture Media Troubleshooting 98
4.8 Conclusion 103
Bibliography 103
5 Microbiological Examination of Non sterile Final Dosage Forms and Raw Material Including Acceptance Criteria and Testing Frequency 105
*David Roesti*
5.1 Microbiological Acceptance Criteria 106
5.2 Testing Frequency 112
5.3 Procedure if Microbial Growth Occurs in Routine Testing 117
5.4 Sampling 117
5.5 Nutrient Medium Controls 120
5.6 Test Method Overview 125
5.7 Verification of the Suitability of the Method 127
5.8 Microbiological Examination of Non sterile Products 142
5.9 Elements to Consider for Raw Data Sheets 148
Acknowledgments 149
Bibliography 149
6 Microbial Requirements and Testing of Primary Packaging 153
*Marcel Goverde*
6.1 Introduction 154
6.2 Guidelines and Literature 161
6.3 Acceptance Criteria and Testing Frequency 164
6.4 Test Methods 170
6.5 Suitability Test 174
6.6 OOS Procedure 177
6.7 Examples of OOS or OOE Cases 178
6.8 Conclusion 184
Bibliography 185
7 Utilities Design and Testing 189
*Tim Sandle*
7.1 Introduction 190
7.2 Defining, Developing, and Maintaining Utilities 191
7.3 Review of Critical Utilities 198
7.4 Conclusion 226
Bibliography 227
8 Microbiological Environmental Monitoring 231
*Alexandra Stärk*
8.1 Introduction 232
8.2 Microbiological Control Strategy 233
8.3 Cleanliness Zoning Concept for Non sterile Products 233
8.4 Microbiological Environmental Monitoring Strategy 234
8.5 Microbiological Environmental Monitoring Methods 235
8.6 Method Validations and Suitability Tests for Microbiological Environmental Monitoring 238
8.7 Initial Validation of Cleanrooms and Production Equipment 244
8.8 Definition of a Microbiological Environmental Routine Monitoring Program 246
8.9 Microbiological Environmental Monitoring: Examples for Users 253
8.10 Conclusion 261
Bibliography 262
9 Identification of Microorganisms 265
*Christine E. Farrance*
9.1 Introduction 266
9.2 History and Challenges of Bacterial Taxonomy and Classification 268
9.3 History and Challenges of Fungal Taxonomy and Classification 276
9.4 Current Identification Technologies 279
9.5 Strengths and Weaknesses with Each Categorical Method 306
9.6 Case Studies from a Contract Testing Lab 309
9.7 Conclusion 313
Bibliography 314
10 Calculating Alert Levels and Trending of Microbiological Data 329
*David Roesti*
10.1 Introduction 330
10.2 Goal of the Chapter 332
10.3 Alert Levels Based on Historical Data 332
10.4 Trending 355
10.5 Conclusion 367
Acknowledgments 367
Bibliography 367
11 Exclusion of Objectionable Microorganisms from Non sterile Pharmaceutical Drug Products 371
*Tony Cundell*
11.1 Introduction 372
11.2 What is an Objectionable Microorganism? 374
11.3 Screening for Objectionable Microorganisms 383
11.4 Risk Based Microbial Testing of Non sterile Drug Products 388
11.5 Sources of Objectionable Microorganisms 389
11.6 Risk Assessment to Determine if a Microorganism is Objectionable in a Non sterile Drug Product 392
11.7 Case Histories 395
11.8 Conclusions 398
Bibliography 399
12 Data Integrity and Microbiological Excursion Handling 401
*David Roesti and Marcel Goverde*
12.1 Data Integrity 401
12.2 General Concept for Microbiological Excursion 410
12.3 Considerations for Excursions 420
Bibliography 427
13 Rapid Microbiological Methods 429
*Michael J. Miller*
13.1 Introduction 429
13.2 The Current State of Microbiology Testing 431
13.3 Rapid Microbiological Methods 432
13.4 Applications for Non sterile Pharmaceutical Drug Products 433
13.5 Technology Review 435
13.6 Validating Rapid Microbiological Methods 447
13.7 Developing a Business Case for Rapid Methods 454
13.8 Summary 455
Bibliography 456
14 Validation of a Rapid Microbiological Method for the Microbiological Examination of Non sterile and Nonfilterable Drug Products, APIs, and Excipients 459
*Oliver Gordon and David Roesti*
14.1 Introduction 460
14.2 Method Validation 462
14.3 Suitability Test (Product Specific Method Validation) 479
14.4 Discussion 483
14.5 Conclusion 486
Acknowledgments 486
Bibliography 487
15 An Ex Regulator's View of the Microbiology QA/QC Functions in the US Pharmaceutical Industries 489
*David Hussong*
15.1 Foods, Drugs, and Quality 489
15.2 Why Microbes Confound a Cen…
